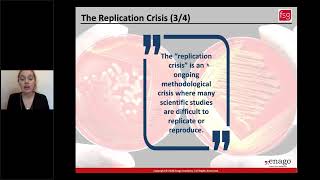

Shared 11 months ago
15 views
Shared 2 years ago
261 views
Shared 6 months ago
12 views
Shared 2 years ago
519 views
Shared 2 years ago
13 views
Shared 1 year ago
16 views
Shared 1 year ago
51 views
Shared 2 years ago
2.8K views
Shared 5 months ago
7 views
Shared 2 years ago
1.3K views
Shared 2 years ago
484 views
Shared 1 year ago
124 views
Shared 2 years ago
590 views
Shared 6 months ago
489 views
Shared 3 months ago
88 views